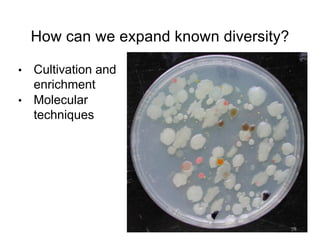
How can we expand known diversity?
• Cultivation and
enrichment
• Molecular
techniques
24

The document outlines the structure and expectations for a microbiology course, emphasizing the use of textbooks, optional synchronous meetings, and the importance of student engagement. Key components include assessment schedules, recommended study hours, and resources for help, as well as a focus on microbial diversity and measurement techniques. It also discusses learning goals for understanding microbial diversity and its implications in ecological and health contexts.